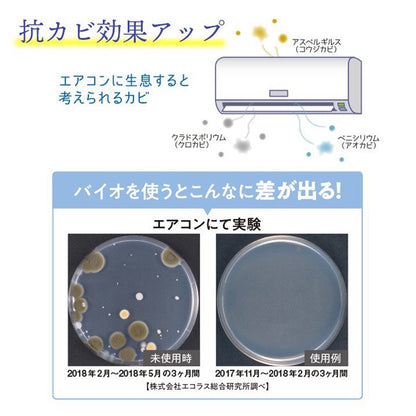

1
/
/
7
Arnest
Arnest - 冷气机专用防霉盒(替换装)
Arnest - 冷气机专用防霉盒(替换装)
常规价格
HK$59.00
常规价格
促销价
HK$59.00
单价
/
单价
无法加载取货服务可用情况
原产地:日本
使用方法:
请先清洁机内的发霉和入风口的灰尘
将产品贴于或钩于冷气机的入风口即可
(为节省不必要支出和响应环保,建议下次使用「替换装」作更换)
注意事项:
为方便更换替换装,请将防霉盒开口方向上放置
请放置于儿童触及不到之处
对已存在的发霉情况效果不明显
请不要同时使用抗菌产品
3匹以上顶置式的机款建议同时使用2个防霉盒
可抑制冷气机内的霉菌生长减少冷气机内的霉菌散播到家居的机会减少霉菌传播到其他地方引致发霉或影响人体健康的机会减少冷气机因发霉而喷出的异味对人、幼童、宠物都安全无害
! !仅替换装一包,没有外盒。